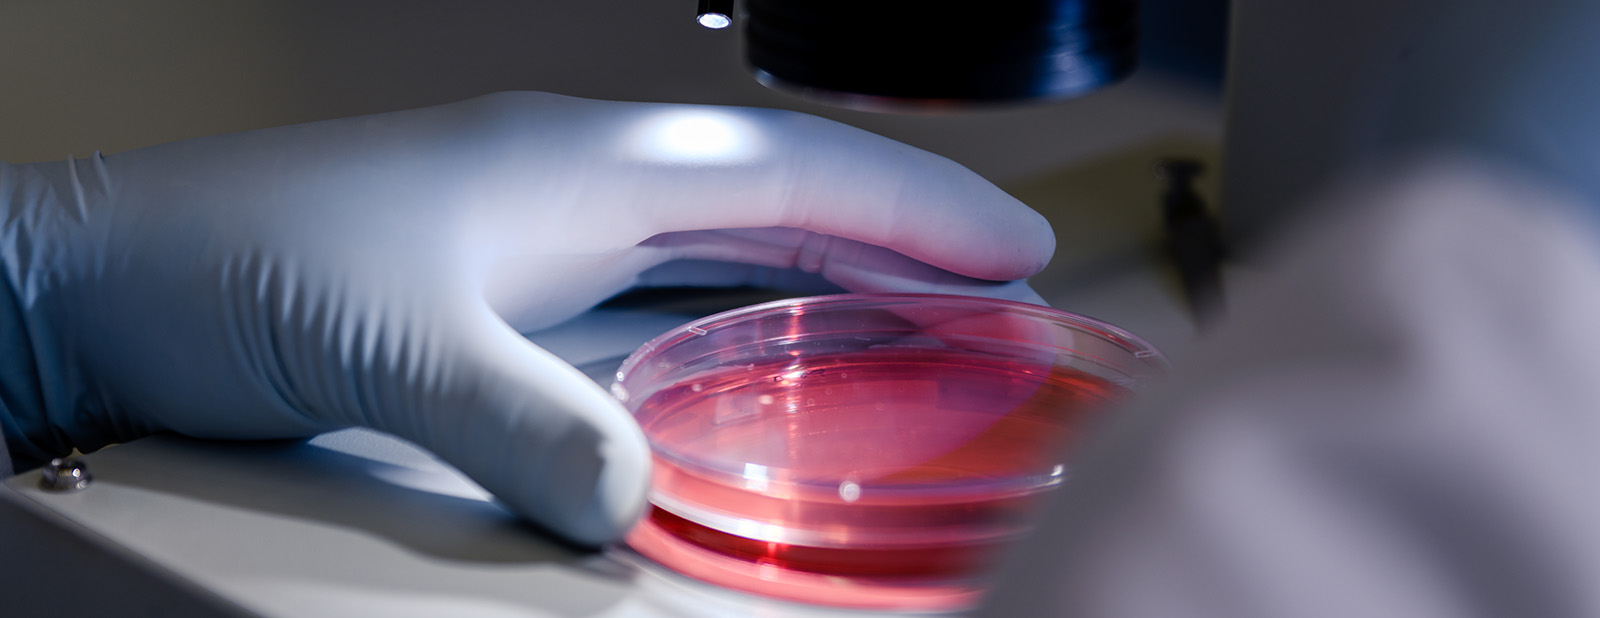

HSBC venture healthcare 1H 2024: mid-year insights
- Innovation
- Report
- 5 minutes read
In 2023, venture healthcare faced a challenging IPO market and limited M&A opportunities, grappling with the valuation and investment froth from 2020–1H 2022. It became the year of triage, with companies closing insider-rounds as investors slowed their pace and prioritized existing portfolios.
On the other hand, 1H 2024 saw increased investment across every sector and numerous new investor-led financings. These deals demonstrated a median step-up of 1.3x, with only 20% experiencing down-rounds. Although many companies still rely on dwindling insider-round cash and will need to find a new lead investor or else face consolidation or shutdown, the industry has largely shaken off 2023's malaise.
Healthtech
In 2023, Healthtech investments significantly declined from Q1 to Q2 due to the banking crisis. The trend reversed in 1H 2024, with deal activity rising each quarter.
The high volume of insider bridges and round extensions decreased in 1H 2024 as investors completed their triage and started to rebuild their portfolio by funding new deals. Although investments took longer to finalize, Healthtech experienced a surge in earlier-stage deals, where valuation overhang is less problematic.
Med Device
Med device investments remained stable, buoyed by a surge in first-financing deals and dollars in 2Q 2024. These deals were led by strong venture capital syndicates, along with some corporate investment. There was also an increase in early-stage investment in deals requiring robust clinical trials, particularly in neurology. Despite stable investment and strong M&A in 2023, private M&A in 1H 2024 has been lackluster, with only two notable private deals.
Biopharma
Exits were a bright spot in 1H 2024 for biopharma, driven by opportunistic IPOs and a strong private M&A market. While Seed and Series A dollars doubled, the number of first-financing deals declined, and the average deal size jumped from $25M to $75M.
Overall investment in biopharma increased by 35% as later-stage deals benefited from the re-entry of crossover investors. In 1H 2024, there were fifty-one private deals exceeding $100M, with thirty of these involving a new crossover investor.
Dx/Tools
Dx/Tools mimicked its 2H 2023 first-financing decline, maintaining stable numbers in 1H 2024 which were markedly lower than the past three years. Early-stage investors were constrained by a closed IPO market and the challenge of securing a Series B investor to bridge to its commercialization growth round.
While early-stage valuations remained strong, companies with lofty valuations from 2020–2021 experienced flat or down rounds. Private M&A activity continues to lag, with just two private M&A deals over $50M upfront in 1H 2024.
Disclosures
HSBC Innovation Banking is a business division with services provided in the United States by HSBC Bank USA, N.A.
DO NOT include personal/account information in this form. Please contact using the business customer service center phone number to discuss any account questions.
Deposit products offered in the United States by HSBC Bank USA, N.A. Member FDIC.
For clients located outside of the U.S. – Our products and services are not specifically directed at individuals located in the European Union. Our U.S. representatives, as well as our public website, us.hsbc.com, provide products and services governed by U.S. laws and regulations. Our products and services, as well as their specific terms and conditions, are subject to change and may not be available in all territories or to all customers. If you are not located in the U.S., the laws and regulations of your country of residence could affect the offering, negotiation, discussion, provision, and/or use of HSBC U.S. products and services. If you are not a U.S. resident, please read the specific cross-border product and service disclaimers, which are available on the Cross Border Disclosure page of our public website at www.us.hsbc.com/crossborder. Deposit products are offered in the U.S. by HSBC Bank USA, N.A. Member FDIC. Lending products are offered in the U.S. by HSBC Bank USA, N.A. Investments and certain insurance products, including annuities, are offered by HSBC Securities (USA) Inc. (HSI), member NYSE/FINRA/SIPC. Whole life, universal life, term life, and other types of insurance are provided by unaffiliated third parties and offered through HSBC Insurance Agency (USA) Inc., a wholly owned subsidiary of HSBC Bank USA, N.A.
* Limitations apply. International calls cover over 190 countries including Western Europe, Canada, Mexico, China and India.
HSBC venture healthcare 1H 2024: mid-year insights